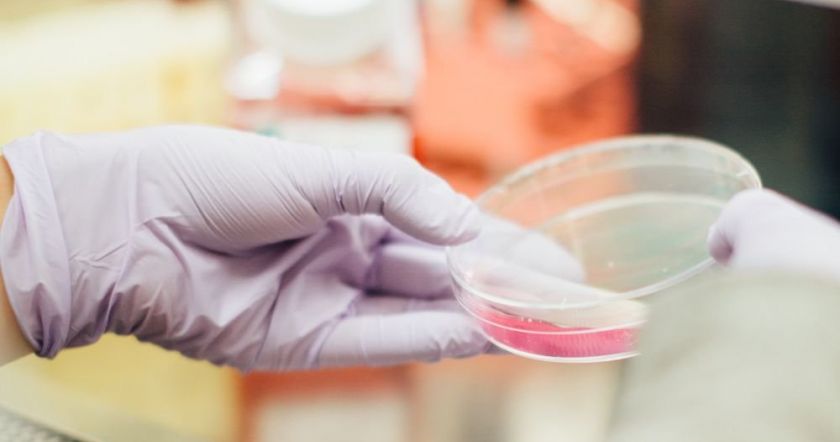

Ученые опасаются, что выявили новую угрозу будущей пандемии - вирус, который живёт в организме африканских обезьян. Речь о вирусе обезьяней геморрагической лихорадки (SHFV), вызывающим разрушительные симптомы, схожие с проявлениями лихорадки Эбола, включая и массивные внутренние кровотечения. В настоящий момент он убивает практически всех приматов, которые им заражаются.
Вирус захватывает иммунную систему и отключает ключевые защитные механизмы, разрушая организм клетка за клетку. Пока среди человека не выявлено ни одного заболевшего, но сам вирус, по словам исследователей, уже достаточно мутировал для того, чтобы перепрыгнуть на человека.
Сейчас следует разрабатывать тесты на этот вирус и отслеживать его распространение, чтобы в зародыше пресечь новую вспышку и не дать ей дорасти до масштабов COVID-19. Исследование проводилось учеными из Университета Колорадо в Боулдере, которые бьют тревогу из-за совместимости SHFV с человеческим организмом, что подтвердили лабораторные исследования. Патоген способен прикрепляться к человеческому рецептору и создавать свои копии.
Cсылка оригинала: https://www.medikforum.ru/medicine/140361-chelovechestvu-ugrozhaet-novyy-smertelnyy-virus.html
Мысли и позиции, опубликованные на сайте, являются собственностью авторов, и могут не совпадать с точкой зрения редакции BlogNews.am.
print
Распечатать







